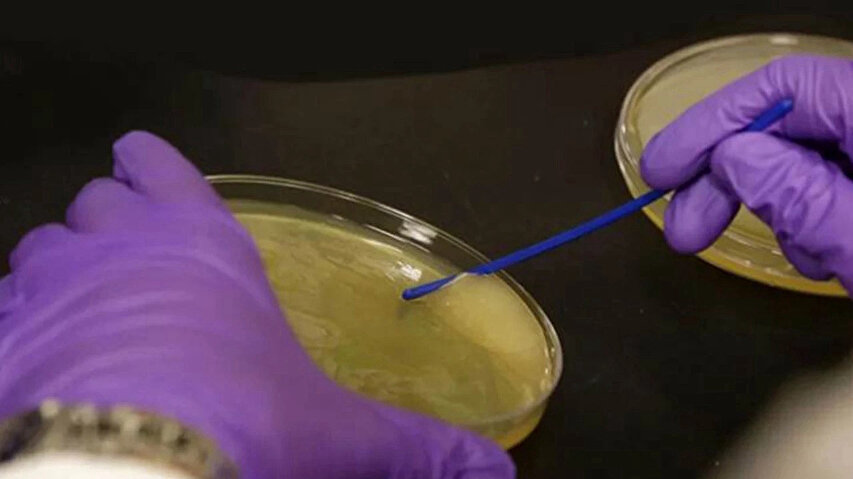

Son günlerde dünyada artan Vibrio vakaları, Türkiye’de de endişeyle takip ediliyor. Sağlık Bakanlığı Halk Sağlığı Genel Müdürlüğü, Türkiye'de "et yiyen bakteri" olarak bilinen Vibrio vulnificus kaynaklı herhangi bir hastalık vakası bulunmadığını duyurdu.
Halk arasında “et yiyen bakteri” olarak bilinen vibrio bakterisi özellikle sıcak ve tuzlu sularda bulunuyor ve açık yaralardan vücuda girerek ciddi enfeksiyonlara yol açabiliyor.
Türkiye'de 'Vibrio vulnificus' kaynaklı vaka var mı?

Açık yaradan vücuda giriyor
Bu bakteri genellikle ılık ve hafif tuzlu deniz suyunda yaşar ve insanların yüzme sırasında açık yaralarından vücuda girebilir.
Sağlık yetkilileri, çiğ kabuklu deniz ürünleri, özellikle de çiğ istiridye tüketiminin de enfeksiyon kaynağı olabileceğini belirtti.
Belirtileri neler?
Vibrio vulnificus genellikle kusma, ishal ve karın ağrısıyla seyreden vibriozis adı verilen bir hastalığa yol açabilir. Ayrıca ciddi cilt enfeksiyonlarına da neden olabilir.
Bakteriyel cilt enfeksiyonunun belirtileri arasında ateş, kızarıklık, ağrı, şişlik, sıcaklık artışı, renk değişikliği ve akıntı yer alıyor.









